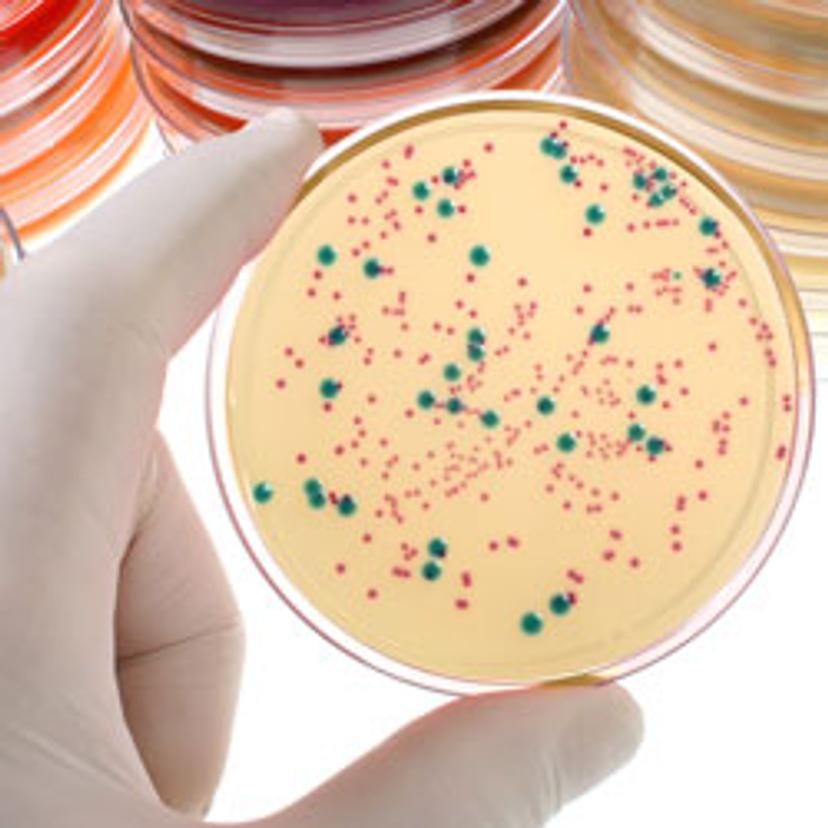

Free Webinar – Automate Colony Picking and Forget About Toothpicks
Learn how to automate colony picking, eliminate picking errors and save time
14 May 2017
In this free webinar, Jana Langhoff, Application Specialist, Tecan, will provide solutions to automate the tedious task of picking colonies off agar plates. Registration for the online event is now open.
Colony picking lies at the heart of many applications, such as molecular cloning, monoclonal antibody production, biofuel development and screening workflows. Although picking colonies by hand is not technically difficult, it is time consuming. With typical throughput demands of more than 1,000 colonies per day, it can easily become error-prone. Automated colony picking not only eliminates picking errors and personal picking preferences, it also makes the process reproducible and traceable.
In this webinar, Jana will introduce SciRobotics’ Pickolo™ Colony-Picker add-on for Tecan liquid handling platforms, describe Pickolo’s unique features, and explain how it can pick bacterial colonies, among other applications. Jana Langhoff holds an MSc in molecular and cell biology, and has been an application specialist at Tecan since 2015, where she supports the SciRobotics’ Pickolo Colony-Picker add-on.
Register for this webinar to learn...
- about the Pickolo Colony-Picker and its unique picking features
- how to increase colony-picking throughout and track the process
- how the combination of colony picking and automated liquid handling can save you time and money
Register now for the live event on 17 May, 2017 - 16:00 BST/17:00 CEST/11:00 EDT/08:00 PDT